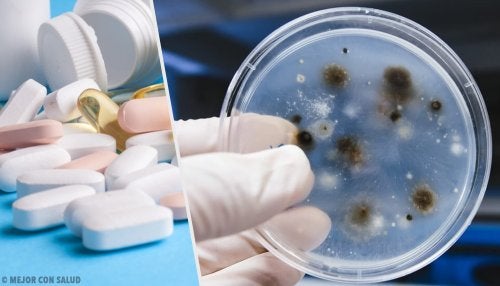
Traitement de la blastomycose

Traitement de la blastomycose
Le traitement de la blastomycose est constitué principalement par des médicaments. Cependant, certaines mesures complémentaires doivent toujours être prises, selon ce que le médecin indique. Parmi ces mesures figurent :
- Bonne alimentation.
- Repos.
- Maintien des horaires de médication.
La blastomycose est une infection qui affecte principalement les poumons causée par le champignon Blastomyces dermatitidis. Celui-ci accède aux voies respiratoires de l’individu atteint par inhalation de ses spores. Il est assez courant de trouver des spores de ce champignon et d’autres dans l’air, en particulier dans les espaces moins pollués par l’activité humaine.
Blastomyces dermatitidis est un pathogène dimorphe présent principalement dans le Midwest et le nord des États-Unis, ainsi que dans certaines régions canadiennes.
L’infection se produit par inhalation de ses spores. Cependant, cela ne se développera que sile système immunitaire de l’individu ne fonctionne pas correctement.
Sinon, les neutrophiles et les macrophages présents dans les alvéoles seront chargés d’éliminer les spores qui se sont glissées dans le système respiratoire.
- La blastomycose est l’une des infections fongiques les moins courantes. Elle affecte principalement les personnes qui travaillent à l’extérieur dans des zones peu habitées.
- Elle était particulièrement pertinente dans la seconde moitié du XXe siècle car il y avait de nombreux cas de bûcherons américains infectés. Pour cette raison et en raison de la localisation de ce champignon, il a été rebaptisé blastomycose américaine.
REMARQUE : Tout d’abord, il convient de tenir compte du fait que l’article présenté ici s’adresse aux étudiants en médecine et non aux patients, car une grande partie des informations fournies ici peuvent ne pas être comprises exactement sans une étude préalable.
Traitement de la blastomycose

Le traitement de la blastomycose consiste principalement en l’administration d’antifongiques modérément agressifs selon la sévérité de l’infection.
La lutte contre les infections fongiques reste une tâche compliquée en raison de la grande similitude entre nos cellules et les cellules fongiques. Cette ressemblance est considérablement plus grande que la ressemblance entre une bactérie et une cellule humaine.
C’est précisément pour cette raison que la science concentre ses efforts sur la recherche de molécules présentes dans les cellules fongiques et absentes dans les cellules humaines, afin de les utiliser comme cibles moléculaires pour de nouveaux médicaments antifongiques. C’est le cas de l’ ergostérol, une molécule présente dans les cellules végétales et qui joue le même rôle que le cholestérol dans les cellules animales.
Visitez cet article : 7 choses à savoir sur les mycoses des ongles que vous devez savoir
Traitement des infections mineures

Les azoles oraux, tels que l’itraconazole, un triazole, sont souvent prescrits aux patients souffrant d’infections légères ou modérées.
- Les azoles sont des molécules de carbone cycliques qui ont au moins un atome d’azote dans leur structure.
Le mécanisme d’action de ces médicaments consiste en :
- L’inhibition d’une enzyme essentielle à la synthèse de l’ergostérol.
- Après avoir désactivé l’enzyme qui médie la synthèse de l’ergostérol, les stérols intermédiaires toxiques commenceront à s’accumuler dans la cellule.
- L’accumulation de ces stérols forcera la cellule à entrer dans un état d’apoptose ou de mort cellulaire programmée.
En bref, les azoles sont des médicaments qui tuent les cellules fongiques sans endommager gravement les cellules humaines. Par conséquent, ils sont très efficaces pour le traitement de la blastomycose et d’autres infections apparentées.
Vous ne le saviez pas ? Renforcez votre système immunitaire et évitez les infections en consommant ces 8 aliments
Traitement des infections modérées ou sévères
Chez les patients présentant des infections plus graves, on administre en premier l’amphotéricine B. Ce médicament appartient au groupe des polyènes, un groupe d’antibiotiques macrolides (un groupe de molécules qui ont le même motif structurel dans leur structure).
Les antibiotiques macrolides sont synthétisés par diverses espèces bactériennes du genre Streptomyces. De plus, l’aspect structural et le mécanisme d’action des polyènes varient très peu d’un à l’autre. Mais quel est son mécanisme d’action ?
- Dans ce cas, ce qui se passe, c’est que les polyènes sont associés à l’ergostérol.
- Par conséquent, des pores vont commencer à se former qui vont altérer la perméabilité de la membrane.
- Cette augmentation de perméabilité va déclencher une perte de nutriments essentiels à la vie de la cellule fongique, comme les protéines, les glucides.
- Pour le traitement de la blastomycose superficielle, le médecin peut choisir de prescrire des polyènes plus agressifs comme la nystatine. Ces médicaments sont plus efficaces, cependant, ils ne peuvent être utilisés que par voie topique.
Le traitement de la blastomycose est constitué principalement par des médicaments. Cependant, certaines mesures complémentaires doivent toujours être prises, selon ce que le médecin indique. Parmi ces mesures figurent :
- Bonne alimentation.
- Repos.
- Maintien des horaires de médication.
La blastomycose est une infection qui affecte principalement les poumons causée par le champignon Blastomyces dermatitidis. Celui-ci accède aux voies respiratoires de l’individu atteint par inhalation de ses spores. Il est assez courant de trouver des spores de ce champignon et d’autres dans l’air, en particulier dans les espaces moins pollués par l’activité humaine.
Blastomyces dermatitidis est un pathogène dimorphe présent principalement dans le Midwest et le nord des États-Unis, ainsi que dans certaines régions canadiennes.
L’infection se produit par inhalation de ses spores. Cependant, cela ne se développera que sile système immunitaire de l’individu ne fonctionne pas correctement.
Sinon, les neutrophiles et les macrophages présents dans les alvéoles seront chargés d’éliminer les spores qui se sont glissées dans le système respiratoire.
- La blastomycose est l’une des infections fongiques les moins courantes. Elle affecte principalement les personnes qui travaillent à l’extérieur dans des zones peu habitées.
- Elle était particulièrement pertinente dans la seconde moitié du XXe siècle car il y avait de nombreux cas de bûcherons américains infectés. Pour cette raison et en raison de la localisation de ce champignon, il a été rebaptisé blastomycose américaine.
REMARQUE : Tout d’abord, il convient de tenir compte du fait que l’article présenté ici s’adresse aux étudiants en médecine et non aux patients, car une grande partie des informations fournies ici peuvent ne pas être comprises exactement sans une étude préalable.
Traitement de la blastomycose

Le traitement de la blastomycose consiste principalement en l’administration d’antifongiques modérément agressifs selon la sévérité de l’infection.
La lutte contre les infections fongiques reste une tâche compliquée en raison de la grande similitude entre nos cellules et les cellules fongiques. Cette ressemblance est considérablement plus grande que la ressemblance entre une bactérie et une cellule humaine.
C’est précisément pour cette raison que la science concentre ses efforts sur la recherche de molécules présentes dans les cellules fongiques et absentes dans les cellules humaines, afin de les utiliser comme cibles moléculaires pour de nouveaux médicaments antifongiques. C’est le cas de l’ ergostérol, une molécule présente dans les cellules végétales et qui joue le même rôle que le cholestérol dans les cellules animales.
Visitez cet article : 7 choses à savoir sur les mycoses des ongles que vous devez savoir
Traitement des infections mineures

Les azoles oraux, tels que l’itraconazole, un triazole, sont souvent prescrits aux patients souffrant d’infections légères ou modérées.
- Les azoles sont des molécules de carbone cycliques qui ont au moins un atome d’azote dans leur structure.
Le mécanisme d’action de ces médicaments consiste en :
- L’inhibition d’une enzyme essentielle à la synthèse de l’ergostérol.
- Après avoir désactivé l’enzyme qui médie la synthèse de l’ergostérol, les stérols intermédiaires toxiques commenceront à s’accumuler dans la cellule.
- L’accumulation de ces stérols forcera la cellule à entrer dans un état d’apoptose ou de mort cellulaire programmée.
En bref, les azoles sont des médicaments qui tuent les cellules fongiques sans endommager gravement les cellules humaines. Par conséquent, ils sont très efficaces pour le traitement de la blastomycose et d’autres infections apparentées.
Vous ne le saviez pas ? Renforcez votre système immunitaire et évitez les infections en consommant ces 8 aliments
Traitement des infections modérées ou sévères
Chez les patients présentant des infections plus graves, on administre en premier l’amphotéricine B. Ce médicament appartient au groupe des polyènes, un groupe d’antibiotiques macrolides (un groupe de molécules qui ont le même motif structurel dans leur structure).
Les antibiotiques macrolides sont synthétisés par diverses espèces bactériennes du genre Streptomyces. De plus, l’aspect structural et le mécanisme d’action des polyènes varient très peu d’un à l’autre. Mais quel est son mécanisme d’action ?
- Dans ce cas, ce qui se passe, c’est que les polyènes sont associés à l’ergostérol.
- Par conséquent, des pores vont commencer à se former qui vont altérer la perméabilité de la membrane.
- Cette augmentation de perméabilité va déclencher une perte de nutriments essentiels à la vie de la cellule fongique, comme les protéines, les glucides.
- Pour le traitement de la blastomycose superficielle, le médecin peut choisir de prescrire des polyènes plus agressifs comme la nystatine. Ces médicaments sont plus efficaces, cependant, ils ne peuvent être utilisés que par voie topique.
Toutes les sources citées ont été examinées en profondeur par notre équipe pour garantir leur qualité, leur fiabilité, leur actualité et leur validité. La bibliographie de cet article a été considérée comme fiable et précise sur le plan académique ou scientifique
- Rezusta, A., Gil, J., & Rubio, M. (2013). Micosis Importadas. Sociedad Española de Enfermedades Infecciosas y Microbiología.
- Montoya, M., Chumbiraico, R., Ricalde, M., Cazorla, E., & Hernández-Córdova, G. (2012). Blastomicosis oral, papilomatosis laríngea y tuberculosis esofágica^iesnOral blastomycosis, laryngeal papillomatosis and esophageal tuberculosis^ien. Rev. Peru. Med. Exp. Salud Publica.
- Sanjay G. Revankar, MD, Professor of Medicine and Director, Infectious Disease Fellowship Program,
Division of Infectious Diseases, Wayne State University School of Medicine
Jack D. Sobel, MD, Dean and Distinguished Professor of Medicine, Wayne State University School of
Medicine. (2019) Blastomicosis -Enfermedades infecciosas- Manual MSD. Recuperado de: https://www.msdmanuals.com/es-es/professional/enfermedades-infecciosas/hongos/blastomicosis
Ce texte est fourni à des fins d'information uniquement et ne remplace pas la consultation d'un professionnel. En cas de doute, consultez votre spécialiste.







